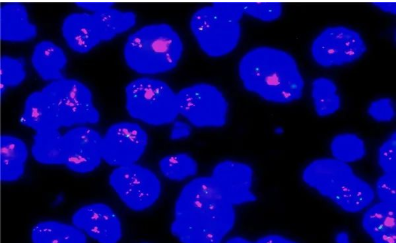
1656034404419305.png image.png

2020年3月至今,红河州第三人民医院病理科成功开展了快速荧光原位杂法(fluorescence in situ hybridization,FISH)检测乳腺润性癌HER2基因 ,现已完成100余例乳腺癌HER2基因检测,为临床靶向药物治疗提供了准确可靠的依据。
目前,该院病理科一般采用免疫组织化学(IHC)检测HER2蛋白的表达水平,应用原位杂交(in situ hybridization)法检测 HER2 基因扩增水平。原位杂交包括荧光原位杂交(fluorescence in situ hybridization,FISH)和亮视野原位杂交。其中免疫组织化学检测方法是蛋白质水平的检测手段,病理科已开展了21年,而FISH技术是一种基因水平的检测方法,通过荧光标记的DNA探针与细胞核内的DNA靶序列杂交,在荧光显微镜下观察并分析细胞核内杂交于DNA靶序列的探针信号,以获得细胞核内染色体(或染色体片段)上基因状态的信息,是一种分子病理测检测方法,是乳腺癌HER2基因检测的“金标准”,目前在红河州内处于领先水平,FISH技术的成功开展,为红河州第三人民医院分子病理的发展奠定了坚实的基础,为临床靶向药物治疗提供了更精准地指导。
研究表明,一种受体型的酪氨酸激酶-人类表皮生长因子受体2(HER2)在20%一30%的原发性乳腺浸润性导管癌中有基因的扩增和蛋白的过度表达。HER2阳性的乳腺癌浸润性强,无病生存期短,预后差。曲妥珠单抗(赫赛汀)是一种重组 DNA衍生的人源化单克隆抗体,适用于治疗 HER2过度表达的乳腺癌。由于,只有 HER2过度表达和基因扩增的乳腺癌患者用曲妥珠单抗治疗才有效,因此,正确检测和评定乳腺癌的 HER2蛋白表达和基因扩增状态对乳腺癌的临床治疗和预后判断至关重要。
HER2阳性乳腺癌患者预后差,无病生存和总生存期缩短,淋巴结转移几率高,复发风险高。HER2阳性乳腺癌患者体内的HER2蛋白过度表达。当HER2成了“癌细胞”的帮凶,刺激癌细胞疯狂地生长和增殖,从而使疾病进展速度比其他类型的乳腺癌更快,导致复发和转移。然而令人欣慰的是,随着分子生物学的不断发展,研究发现应用靶向药物(赫赛汀)可以阻断HER2信号传导通路,抑制肿瘤细胞的增殖,从而达到治疗乳腺癌的目的。因此,明确HER2是否过表达在乳腺癌诊疗中显得尤其重要,而HER2的状态更是重要的预后指标和靶向HER2药物的治疗靶点。抗HER2靶向治疗就是应用靶向药物通过阻断HER2信号传导通路,进而抑制肿瘤细胞的增殖,达到治疗乳腺癌的目的。
(文/图 高艳)